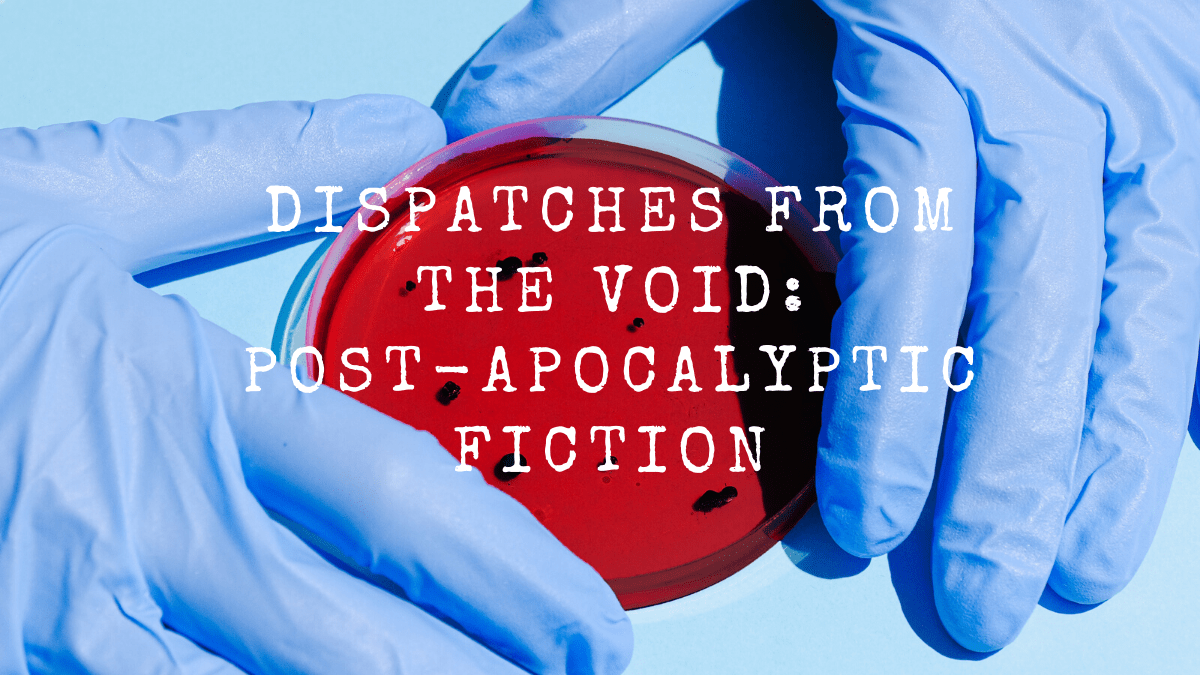

When I found out that I would be stuck in Colorado, without physical access to a public library, for a significant period of time, I told myself that I would read all of the books I own but have never read before. Some of these I bought new or used, some of these I brought home after my grandmother passed away in 2015, others are things I’d collected or been given and have never made it to.
I’m a few weeks in to my exile in Boston, and while I have a read some of these books from my “Books I haven’t read yet” collection, I’ve not read as many as I would have liked to by now.
What I’ve done instead is put quite a few e-books on hold through Libby to read on my resurrected Kindle. Among those books are some post-apocalyptic reads, because that seemed fitting given current circumstances.
Station Eleven by Emily St. John Mandel

I put Station Eleven on my pandemic reading list in part because I saw somewhere (probably twitter), that it was about a plague, and then life 20ish years after the initial outbreak of that devastating disease. I’m into books that talk about life after apocalypse, not just initial apocalypse, more on that later in this post, so it seemed like something I would be into. I’ve also had this book recommended to me multiple times over, so it seemed like it was about time I get around to reading it.
First and foremost, I kind of think Emily St. John Mandel may be a genius, because I thought this was an incredibly well written book. While it’s told in multiple perspectives across multiple time period before, during, and well after the immediate outbreak of the “Georgia Flu,” by and large it centers around the Traveling Symphony, a symphony/Shakespearean troupe that travels around the Great Lakes region twenty years after the initial outbreak.
I love the idea of a post-apocalyptic Shakespearean troupe with all my being even though I’m not actually a huge Shakespeare fan. What stuck with me the most after reading this book is the idea that not only does life go on in the event of unspeakable tragedy but there will still be art.
One line of import in Station Eleven comes from a Star Trek episode, “Survival is insufficient.” This line really hammers home the idea for me that art (music, theater, literature, etc..) is so important to human existence, because still creating and sharing art goes so far beyond survival in the context of this novel.
Station Eleven was published in 2014 and I wish I would have read it far before now, but I found it to be an oddly comforting reading during these troubled times.
Feed by Mira Grant

I read Station Eleven first because my hold on it came in first, but when I decided to read some post-apocalyptic fiction, Feed was the first book that popped into my mind.
Similar to Station Eleven, Feed is also set twenty years after an initial outbreak, but rather than a deadly flu, this time around it was a virus mutation that created Zombies. Georgia and Shaun Mason are sibling journalists (in a future where blogging is the primary way to consume the news) on the campaign trail with Senator Ryman as he makes a run for president. Conspiracies and bio-terrorism ensue.
The first time I read Feed, I was a freshman in high school. As an unsocial 14-year-old who hadn’t joined the pep-band yet, I really didn’t care to go to high school sporting events, but I drug this book along when I went to a basketball game with my dad. When we got home, I stayed up to finish reading the book.
I’ve always been an emotional reader, but Feed is the first book I can remember reading where actual physical tears were pouring out of my face at an alarming rate when a certain plot point occurred.
This book was the one where I realized it’s much more fun to read about the ways in which humanity survives and adapts after a massive trauma, rather than reading about how the initial trauma is dealt with (not that those books can’t be fun at times).
It’s safe to say that I have a connection to this book, and I reread it a few times while I was still in high school. So, when I decided I wanted a few post-apocalyptic reads, of course this had to be one of them.
Clearly, since I was a freshman in high school I’ve become a much more discerning and critically competent reader. So, I don’t think it was any huge surprise that when reading this book for the first time at least four years, that I found it to be a lot different.
It turned out that the biggest difference I found was that this book just doesn’t come across as well-written to me anymore. The world-building is easily the best part of this book and I love just how well thought out and explained the viral mutation that creates zombies is.
However, there’s so much repetition (getting a clean blood test is a big deal, and so so so much focus is placed on that all the time), and I don’t think that the main characters are as well explored as they could be given the length of this novel (almost 600 pages).
That being said, if you’re into journalism and journalistic ethics and cool world building, and can ignore or move past some unnecessary filler material, I would still recommend this read.
On Reading Post-Apocalyptic Fiction in Troubling Times
I’m sure that there are a lot of people out there who want nothing to do with post-apocalyptic fiction right now. It’s tempting, and awesome, to reread comforting childhood favorites (I just reread Beverly Cleary’s Beezus and Ramona this afternoon, and where it’s snowed about a foot in Colorado today, I might pick up Laura Ingalls Wilder’s The Long Winter).
But I don’t just want to be comforted right now, because at some point there has to be a reckoning with the real world. Because things are not normal right now. I’m not in Boston finishing my first year of grad school. I’m dreading a day that may be coming where I find out that I can’t go to Maine and spend the summer working at one of my favorite places ever. I’m trying to take online classes for the first time ever, and not by choice (I do not make a great online student).
For me, these post-apocalyptic reads have been a way to challenge me to break out of the mindset of solely comfort. But as I’ve mentioned, both books I’ve read focus on survival (and the insufficiency of just survival), year beyond the initial outbreaks. I’m reading books that are about “new normals” (something I think we all are establishing right now) and books that about art and truth and the way we build relationships with people in troubling times.
Read what you want to read right now, I’m certainly not reading only post-apocalyptic books. But I found it to be a good thought experiment right now. So even though I’ll be reading other things, I’m also going to finish the Newsflesh Trilogy (of which Feed is the first installment), because despite for years proclaiming that Feed is my favorite zombie novel, I’ve never actually read the entire trilogy.
One thought on “Dispatches from the Void: Post-Apocalyptic Fiction”